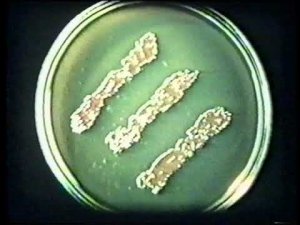

16:19
16:19
2023-06-02 22:57

 46:36
46:36

 46:36
46:36
2024-09-27 18:09

 1:25:42
1:25:42

 1:25:42
1:25:42
2024-09-30 20:00

 1:09:36
1:09:36

 1:09:36
1:09:36
2024-09-25 17:56

 32:07
32:07

 32:07
32:07
2024-09-30 15:00

 45:46
45:46

 45:46
45:46
2024-09-30 17:31

 1:01:35
1:01:35

 1:01:35
1:01:35
2024-09-25 19:21

 58:46
58:46

 58:46
58:46
2024-09-27 18:00

 27:00
27:00

 27:00
27:00
2024-10-01 01:30

 30:22
30:22

 30:22
30:22
2024-09-29 12:00

 29:05
29:05

 29:05
29:05
2024-09-26 12:57

 11:09
11:09
11:09
11:09
2023-06-04 23:20

 18:17
18:17

 18:17
18:17
2023-06-04 14:08

 49:51
49:51

 49:51
49:51
2024-10-02 15:57

 2:02:01
2:02:01

 2:02:01
2:02:01
2024-09-29 23:00

 1:53:18
1:53:18

 1:53:18
1:53:18
2024-09-28 21:00

 32:10
32:10

 32:10
32:10
2024-09-30 11:00

 39:25
39:25
![Динара Швец - Новая история (Премьера клипа 2025)]() 3:45
3:45
![Премьера клипа! Ваня Дмитриенко - Настоящая]() 3:33
3:33
![M1DNITE - Ghost Touch]() 3:36
3:36
![Lx24 - Сберегу (Премьера клипа 2025)]() 2:57
2:57
![Рейсан Магомедкеримов - Забываю (Премьера клипа 2025)]() 3:20
3:20
![Рустам Батербиев - Пора расстаться (Премьера клипа 2025)]() 2:38
2:38
![Anette - Erjanik em (Official Video 2025)]() 3:36
3:36
![Премьера клипа! Артур Пирожков - ALARM]() 3:22
3:22
![Азиз Абдуллох - Аллохнинг айтгани булади (Премьера клипа 2025)]() 3:40
3:40
![W24 - I Gotta Feeling]() 3:49
3:49
![Азамат Ражабов - Отам (Премьера клипа 2025)]() 4:38
4:38
![Taylor Swift - The Fate of Ophelia (Official Video 2025)]() 3:58
3:58
![Игорь Крутой - Зонтик (Премьера клипа 2025)]() 4:00
4:00
![Наталья Влади - А я такая (Премьера клипа 2025)]() 2:21
2:21
![Ислам Итляшев - Скандал (Премьера клипа 2025)]() 2:08
2:08
![Ольга Бузова - Не надо (Премьера клипа 2025)]() 3:15
3:15
![MARSO - Дура (Премьера клипа 2025)]() 3:05
3:05
![Анвар Нишонов - Тулкилар (Премьера клипа 2025)]() 3:38
3:38
![Олег Семенов - Бархатный сезон (Премьера клипа 2025)]() 3:51
3:51
![ИЮЛА - Ты был прав (Премьера клипа 2025)]() 2:21
2:21
![Путь рыцаря | A Knight's War (2025)]() 1:43:53
1:43:53
![Обитель | The Home (2025)]() 1:34:43
1:34:43
![Вне юрисдикции | Exterritorial (2025)]() 1:49:09
1:49:09
![Соник 3 в кино | Sonic the Hedgehog 3 (2024)]() 1:50:21
1:50:21
![Французский любовник | French Lover (2025)]() 2:02:20
2:02:20
![Блиц | Blitz (2024)]() 2:00:30
2:00:30
![Долина эха | Echo Valley (2025)]() 1:44:37
1:44:37
![Полный нокаут | K.O. (2025)]() 1:26:53
1:26:53
![Электрический штат | The Electric State (2025)]() 2:08:34
2:08:34
![Пойман с поличным | Caught Stealing (2025)]() 1:46:45
1:46:45
![Богомол | Samagwi (2025)]() 1:53:29
1:53:29
![Источник вечной молодости | Fountain of Youth (2025)]() 2:05:22
2:05:22
![Дьявол | Diablo (2025)]() 1:31:20
1:31:20
![Бастион 36 | Bastion 36 (2025)]() 2:04:58
2:04:58
![Стив | Steve (2025)]() 1:33:34
1:33:34
![Счастливчик Гилмор 2 | Happy Gilmore (2025)]() 1:57:36
1:57:36
![Откровения | Revelations (2025)]() 2:02:28
2:02:28
![Опустошение | Havoc (2025)]() 1:47:26
1:47:26
![Финикийская схема | The Phoenician Scheme (2025)]() 1:41:27
1:41:27
![Диспетчер | Relay (2025)]() 1:51:56
1:51:56
![Мотофайтеры]() 13:10
13:10
![Рэй и пожарный патруль Сезон 1]() 13:27
13:27
![Последний книжный магазин]() 11:20
11:20
![Синдбад и семь галактик Сезон 1]() 10:23
10:23
![Мартышкины]() 7:09
7:09
![МиниФорс Сезон 1]() 13:12
13:12
![Сборники «Зебра в клеточку»]() 45:30
45:30
![Кадеты Баданаму Сезон 1]() 11:50
11:50
![Чуч-Мяуч]() 7:04
7:04
![Тёплая анимация | Новая авторская анимация Союзмультфильма]() 10:21
10:21
![Шахерезада. Нерассказанные истории Сезон 1]() 23:53
23:53
![Отряд А. Игрушки-спасатели]() 13:06
13:06
![Лудлвилль]() 7:09
7:09
![Паровозик Титипо]() 13:42
13:42
![Супер Зак]() 11:38
11:38
![МегаМен: Полный заряд Сезон 1]() 10:42
10:42
![Таинственные золотые города]() 23:04
23:04
![Пакман в мире привидений]() 21:37
21:37
![Люк - путешественник во времени]() 1:19:50
1:19:50
![Космический рейнджер Роджер Сезон 1]() 11:32
11:32

 39:25
39:25Скачать видео
| 192x144 | ||
| 480x360 | ||
| 640x480 |
 3:45
3:45
2025-10-15 10:45
 3:33
3:33
2025-10-18 17:45
 3:36
3:36
2025-10-12 18:00
 2:57
2:57
2025-10-11 12:26
 3:20
3:20
2025-10-16 11:19
 2:38
2:38
2025-10-16 11:06
 3:36
3:36
2025-10-18 10:11
 3:22
3:22
2025-10-20 15:41
 3:40
3:40
2025-10-18 10:34
2025-10-12 18:28
 4:38
4:38
2025-10-11 12:52
 3:58
3:58
2025-10-17 11:48
 4:00
4:00
2025-10-18 10:19
 2:21
2:21
2025-10-14 11:07
 2:08
2:08
2025-10-14 10:40
 3:15
3:15
2025-10-18 10:02
 3:05
3:05
2025-10-17 11:37
 3:38
3:38
2025-10-11 12:45
 3:51
3:51
2025-10-16 10:57
 2:21
2:21
2025-10-18 10:16
0/0
 1:43:53
1:43:53
2025-07-16 20:59
 1:34:43
1:34:43
2025-09-09 12:49
 1:49:09
1:49:09
2025-08-13 10:53
 1:50:21
1:50:21
2025-01-23 19:58
 2:02:20
2:02:20
2025-10-01 12:06
 2:00:30
2:00:30
2025-01-18 21:22
 1:44:37
1:44:37
2025-08-03 10:47
 1:26:53
1:26:53
2025-06-20 15:43
 2:08:34
2:08:34
2025-03-21 19:58
 1:46:45
1:46:45
2025-10-02 20:45
 1:53:29
1:53:29
2025-10-01 12:06
 2:05:22
2:05:22
2025-05-30 00:57
 1:31:20
1:31:20
2025-06-25 14:54
 2:04:58
2:04:58
2025-04-26 17:36
 1:33:34
1:33:34
2025-10-08 12:27
 1:57:36
1:57:36
2025-08-21 17:43
 2:02:28
2:02:28
2025-04-25 00:41
 1:47:26
1:47:26
2025-08-02 13:33
 1:41:27
1:41:27
2025-06-30 07:40
 1:51:56
1:51:56
2025-09-24 11:35
0/0
 13:10
13:10
2024-11-27 14:57
2021-09-22 23:51
 11:20
11:20
2025-09-12 10:05
2021-09-22 23:09
 7:09
7:09
2025-04-01 16:06
2021-09-23 00:15
 45:30
45:30
2025-09-17 18:49
2021-09-22 21:17
 7:04
7:04
2022-03-29 15:20
 10:21
10:21
2025-09-11 10:05
2021-09-22 23:25
 13:06
13:06
2024-11-28 16:30
 7:09
7:09
2023-07-06 19:20
 13:42
13:42
2024-11-28 14:12
2021-09-22 22:07
2021-09-22 21:43
 23:04
23:04
2025-01-09 17:26
 21:37
21:37
2024-11-28 17:35
 1:19:50
1:19:50
2024-12-17 16:00
2021-09-22 21:49
0/0

